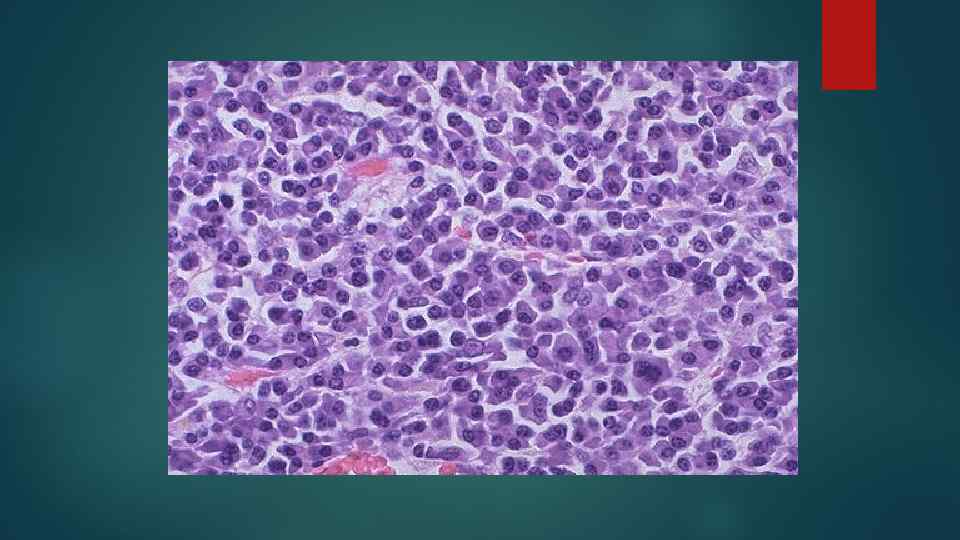

Лимфоидная ткань фото - найдено 30 изображений
Найдено изображений: 30

Смотрите также
- Актеры ментовские войны 9 сезон фото
- Афрокосички на короткие волосы женские фото
- Барселона достопримечательности фото и описание
- Джинсы монтана фото
- Доктор караева ул абубакарова 22 махачкала фото
- Как выглядит значок фар
- Как выглядит татарский флаг смайлик
- Крестики для плитки фото
- Ногти морской волны фото
- Огромные коты фото